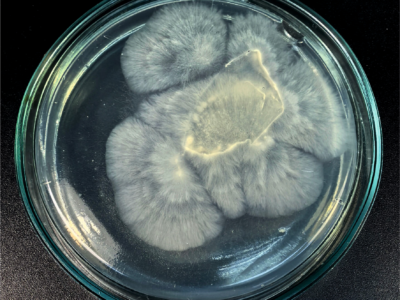
Искусственный интеллект помог калужским ученым ускорить рост грибов Искусственный интеллект помог калужским ученым ускорить рост грибов

Искусственный интеллект помог калужским ученым ускорить рост грибов
В рамках проекта «Калужский ковчег» был проведен эксперимент с применением искусственного интеллекта. Алгоритм оптимизировал состав питательной среды для выращивания мицелия. В результате на подобранных ИИ средах грибные штаммы продемонстрировали иную скорость роста по сравнению с использованием традиционных методик. Ученые планируют продолжить опыты, чтобы закрепить успех. Цель проекта — сохранить редкие грибы области с помощью передовых […]